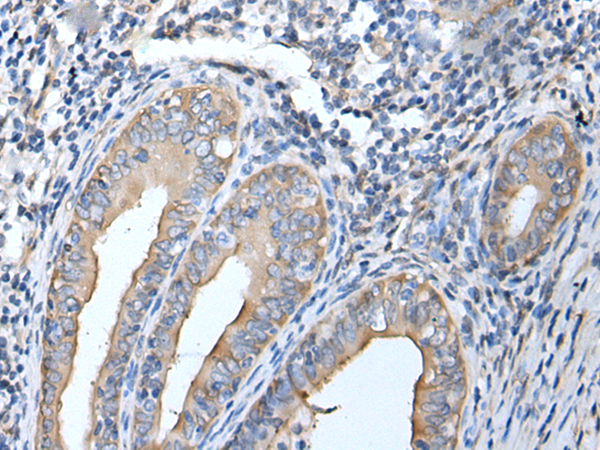
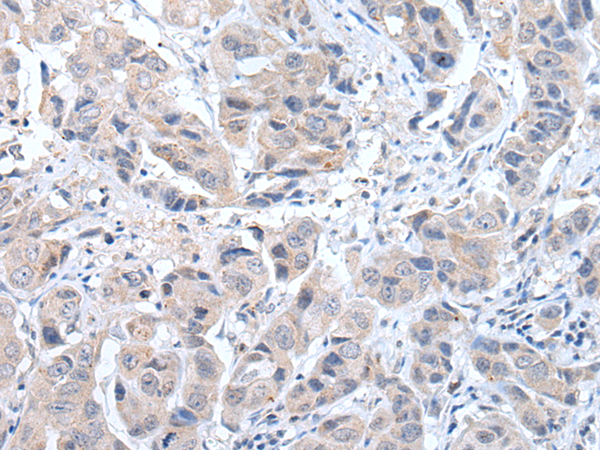
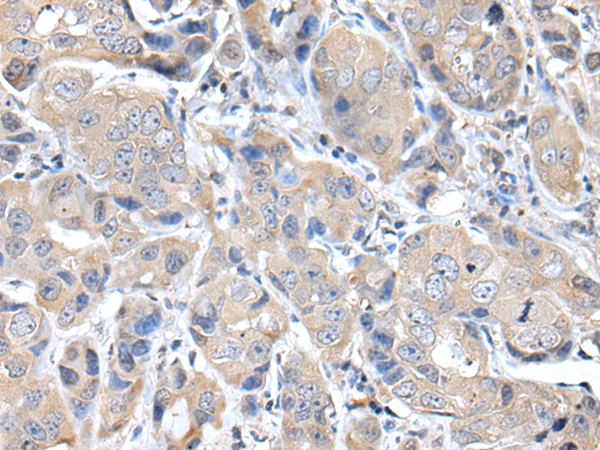

-
分类: 科研抗体货号: P12748别名: CMT2F; HMN2B; HSP27; HSP28; Hsp25; SRP27; HS.76067; HEL-S-102应用: WB,IHC反应种属: Human
-
分类: 科研抗体货号: P12726别名: ABAD; CAMR; ERAB; HCD2; MHBD; HADH2; MRPP2; MRX17; MRX31; SCHAD; MRXS10; SDR5C1; 17b-HSD10; DUPXp11.22应用: WB反应种属: Human, Mouse, Rat
-
分类: 科研抗体货号: P12765别名: LIR8; CD85C; LIR-8应用: WB,IHC反应种属: Human
-
分类: 科研抗体货号: P12747别名: AdPLA; HRSL3; HRASLS3; HREV107; PLA2G16; PLAAT-3; H-REV107; HREV107-1; HREV107-3; H-REV107-1应用: IHC反应种属: Human, Mouse, Rat
-
分类: 科研抗体货号: P12725别名: p56DOK; p56dok-2应用: WB,IHC反应种属: Human, Mouse
-
分类: 科研抗体货号: P12763别名: SLEB10应用: WB,IHC反应种属: Human, Mouse
-
分类: 科研抗体货号: P12746别名: HOX4H应用: IHC反应种属: Human, Mouse
-
分类: 科研抗体货号: P12724别名: CSM1; CSM2; LGMD2R应用: WB,IHC反应种属: Human, Mouse, Rat
-
分类: 科研抗体货号: P12762别名: IRF-2应用: WB反应种属: Human, Mouse
-
分类: 科研抗体货号: P12744别名: HOX4; HOX1D; HOX4A; Hox-4.1应用: WB,IHC反应种属: Human, Mouse

鄂公网安备42018502007531号
鄂公网安备42018502007531号

